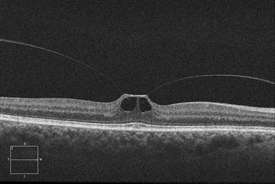

Vitreomacular Traction Syndrome
What is Vitreomacular Traction Syndrome?
The vitreous humor is a transparent, gel-like material that fills the space within the eye between the lens and the retina. The vitreous is encapsulated in a thin shell called the vitreous cortex, and the cortex in young, healthy eyes is usually sealed to the retina.
CAUSES
Age-related degeneration of the gel-like vitreous humor leads to the formation of pockets of fluid within the vitreous, causing contraction and loss of volume. The separation of the vitreous gel from the retina occurs as a result of the gel becoming liquid (liquefaction) and the continuous anterior-posterior (front-back) and tractional forces stretching on the macula over time.
SYMPTOMS
The most common symptoms experienced by patients with VMT syndrome are:
- Decreased sharpness of vision
- Photopsia, when a person sees flashes of light in the eye
- Micropsia, when objects appear smaller than their actual size
- Metamorphopsia, when vision is distorted to make a grid of straight lines appear wavy or blank

